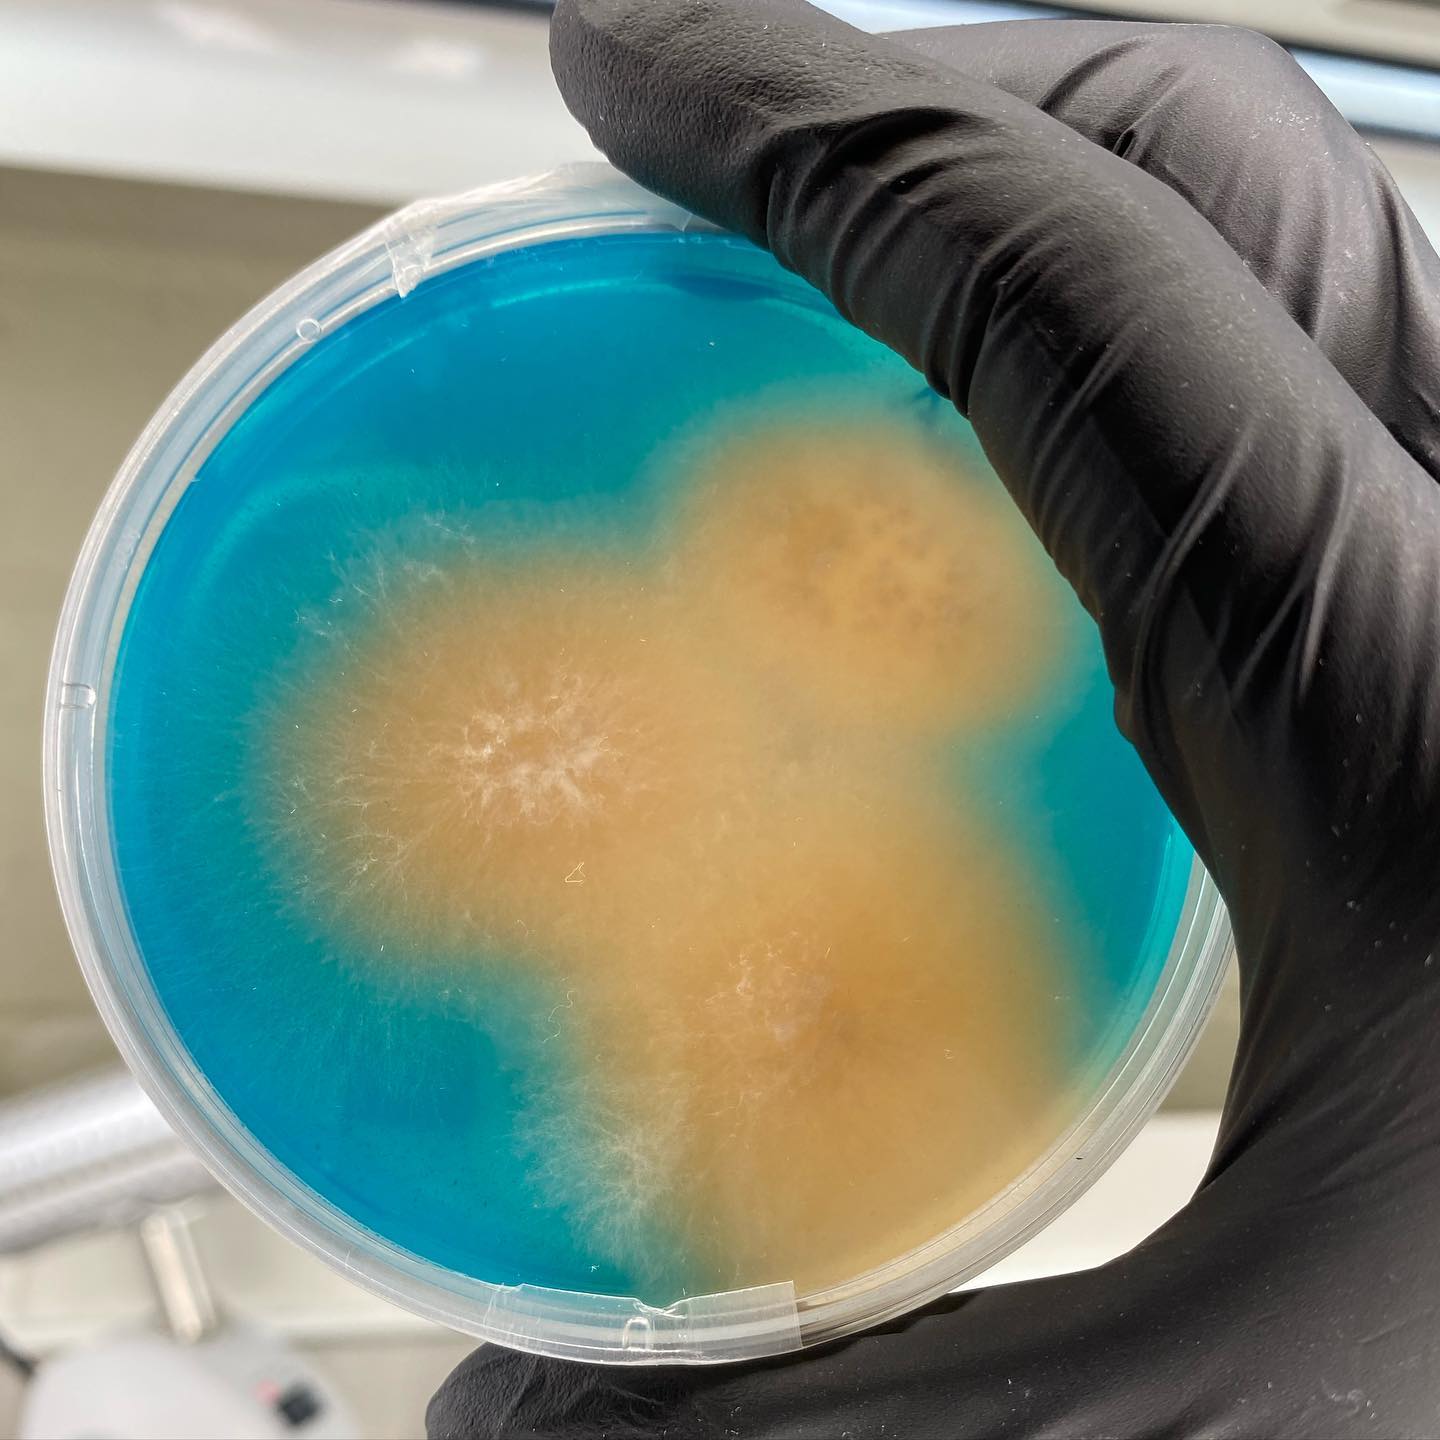

Pure Mushrooms - Pure Purpose
Harness the power of Lion’s Mane with our pure, filler-free, fruiting body powder.
The powder dissolves easily in my morning coffee, making it an effortless addition to my routine. I’ve noticed a boost in mental clarity and focus throughout the day—no more mid-afternoon brain fog! It’s great to know I’m supporting my brain health with such a natural supplement.
I started taking Sisu lion’s mane powder several months ago for all of the health benefits (brain health, immunity, gut health, etc) and have absolutely loved this. I do the auto-ship and just as my container is getting a little low, my new one arrives so I never even have to think about it. Definitely recommend.
The Mycelium Mindset
-

Lion's Mane Benefits and Studies
Lion’s Mane Mushroom (Hericium erinaceus) has gained attention for its potential health benefits, with research beginning to explore how it...
-

Ok I grew the mushrooms, now what?
Gourmet Mushrooms can be intimidating to some, we hope these easy mushroom recipes can help. This is a reminder that...
-

Farming to Supplements: How did we get here?
The Harpers’ journey began in Suffolk, England, during their service in the United States Air Force. Inspired by Tim Ferriss's work,...